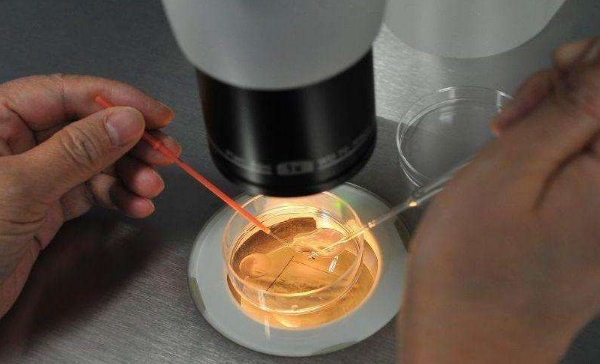

在线咨询
美国试管婴儿如何提高卵子受精率?
在深受业界与广大难孕育家庭高度赞扬和好评的美国梦美EDEN生殖医院,专家遵循科学安全的助孕原则,秉承着健康优生的行医理念,从实际出发,为每位客户制定专属合适的诊疗方案,运用先进的试管技术帮助切实解决生育难题,实现宝宝梦想,让家庭完整。对此,有的客人问道:赴美做试管婴儿如何提高卵子的受精率?
美国试管婴儿如何提高卵子受精率?

美国梦美EDEN专家介绍说,卵子和精子是生命的根源,若是精卵质量差、活力低、染色体异常或畸形,亦或卵子发育不成熟,那么就极有可能会导致不能成功受精,从而影响试管成功率。因此,赴美做试管婴儿,提高卵子受精率的关键是获得优质健康的卵子和精子,然后专家再运用先进的单精子注射技术(ICSI)显著提高受精率,帮助顺利完成试管诊疗周期,获得健康的孩子,实现生育梦想。具体以下详细解析:
1、提高精卵质量

赴美试管前,美国梦美EDEN专家建议夫妻双方先调养好身体,提高卵子和精子的质量,为试管奠定坚实的基础。例如在饮食方面要做到健康饮食、营养均衡,可多食用一些抗氧化的水果(如草莓、蓝莓等)和高蛋白、高纤维、易消化的食物,以及补充多种维生素;减少或者不喝含咖啡因的饮料,戒烟戒酒;同时,女性可每天服用400-600mg辅酶Q10来延缓卵巢的衰老、提高卵子质量;男性则可以服用男宝胶囊提高精子活力,减少精子碎片率,从而提高精子的品质。
此外,要坚持锻炼身体,每天有氧运动半小时以上,比如慢跑、游泳等。并且避免熬夜,保持充足的睡眠;调整好心态、减少压力、保持愉快的心情,为试管助孕加分。
2、科学促排和精子洗涤

科学促排,获得优质成熟的卵子:进入试管周期后,美国梦美EDEN专家会根据女性的实际情况(年龄、卵巢功能和基础卵泡数量等)制定合适的促排方案,通过合理使用药物进行促排,且在用药期间进行实时跟踪和监测,结合女性对药物的反应进行调整,以促使卵巢内多颗卵泡发育至成熟,提高获卵率,帮助获得优质成熟的卵子,为试管后续环节打下良好的基础。

精子洗涤:为了保证精子的质量,美国梦美EDEN专家会运用全新的Perecoll梯度离心精子洗涤技术对提取的精液进行洗涤优化,可去除死掉的精子、炎症精子、精子抗体、炎症细胞等不利受精的成分,然后再通过高倍速的显微镜从中挑选出形态正常、活力强的精子。
3、单精子注射-提高受精率
在获得优质精子和卵子的基础上,美国梦美EDEN专家再运用单精子注射技术(ICSI)将优质的精子直接注射到卵子内,提高受精率。专家表示,该项技术跨越了精子运动、精子发生顶体反应释放顶体酶,颗粒细胞消化,精卵结合,透明带反应等一系列的步骤,能够显著提高卵子的受精率,目前已经达到99%以上。
提示:在美国梦美EDEN医院,ICSI技术均由经验丰富的生殖专家在设备高端的胚胎实验室里进行(实验室配备有高端的医疗设备和仪器,其中包括ICSI设备,能够为单精子注射提供有利保障),所以操作更准确,成功率更高。
专家介绍说,第二代试管婴儿单精子注射技术(ICSI)的研发和临床运用,标志着人类辅助生殖技术进入到了一个全新的阶段,且如今经过几十年的成熟发展已取得了巨大的进步。美国试管婴儿专家借助显微操作系统将单一的精子注射到卵子内使其受精,能够大大提升卵子的受精率,进而提高IVF成功率。
美国先进试管技术-助健康优生,圆生育之梦!
致力于为客户提供先进的辅助生殖技术和高质量的医疗服务,美国梦美EDEN配备了世界先进的医疗设备和资历深厚生殖专家,他们通过多年丰富的诊疗经验为有生育需求的客户制定专属合适的试管方案,以及运用娴熟掌握的先进技术帮助解决生育难题,助健康优生。

在试管周期中,为了保障胚胎健康,提高着床率及妊娠质量,在单精子注射之后美国梦美EDEN专家是先将受精卵放置在专门研制的高质量培养液中培育至第五天,形成结构稳定、生命力旺盛且活性强的优质囊胚(临床研究表明:囊胚更符合子宫的生理状态,将囊胚植入后能够与子宫内膜呈现同步趋势,更容易继续生长发育,所以移植成功率更高)。
之后,美国梦美EDEN专家再运用PGS/PGD基因检测技术对囊胚的23对染色体进行筛查诊断,对比分析囊胚是否存在染色体异常(缺失、倒置、易位、重复等)的情况,或是对基因突变点进行检测,诊断是否携带遗传缺陷的基因或可能导致特定致病基因突变,再择优挑选健康的囊胚植入女性的子宫内,从根源上保障宝宝的健康,实现优生优育。
美国梦美EDEN伊甸园医院作为辅助生殖行业的标杆,专家在多年的医疗实践中形成了套独特完整且行之有效的诊疗体系和方法,会根据每位客户的实际情况为之制定专属的诊疗方案,并且在整个试管诊疗周期中,专家会严格把控每项助孕环节,专业规范操作,为您试管诊疗周期保驾护航,帮助显著提高卵子受精率,助早日完成生育梦想,绽放生命之美!
上一篇 > 走进梦美EDEN,了解美国试管婴儿医疗体系优势
下一篇 > 输卵管堵塞赴美做试管,成功率高不高?